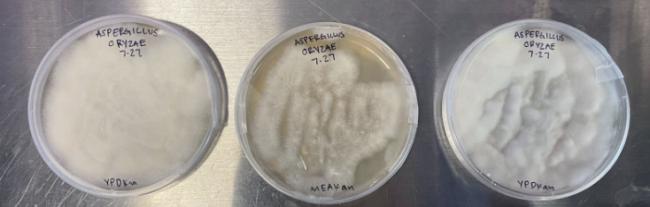

Please wait...
About This Project
Anthropogenic influence on the Earth has had a negative effect. We need to create a sustainable way of living. Using fungi to replace non-sustainable processes is a way. Genetic engineering is an effective tool to enhance or modify particular properties of an organism to make them more functional. We plan to test and open source a variety of protocols for genetic engineering of fungi that will allow people to make fungi that can outcompete standard non-sustainable processes.
More Lab Notes From This Project

Browse Other Projects on Experiment
Related Projects
Highly-sensitive, real-time enzyme methane oxidation rate measurements using an electrochemical assay
A low-cost, rapid, and highly sensitive assay is needed to measure methane gas oxidation rates by methane...
Engineering of a suction cup stethoscope for non-invasive monitoring of physiological sounds in baleen whales
Baleen whales are large-bodied predators that, despite their critical role in marine ecosystems, our understanding...
Building a better fish: Engineering fish for smarter aquaculture
What if we built a better fish instead of depleting wild fisheries? Natural stocks can’t keep up with demand...